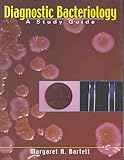
Bergey Bergey

Bergey's Manual of Determinative Bacteriology / Edition 9 by John G. Holt, Peter H. Sneath (Editor), Noel R. Krieg (Editor). I need this book for my researches .. Bergey's Manual of Determinative Bacteriology Ninth Edition. by John G. Holt PhD (Author). Shop for Bergey's Manual of Determinative Bacteriology: (9th edition) from WHSmith. Thousands of products are available to collect from store or if your order's .. 9. ed., [Nachdr. Philadelphia Lippincott Williams & Wilkins. 4. Bergey's manual of determinative bacteriology, 4. Bergey's Manual of Determinative Bacteriology, 9th ed.; find Sigma-Aldrich-B0411 MSDS, related peer-reviewed papers, technical documents, similar products .. Buy Bergey's Manual of Determinative Bacteriology 9th edition (9780683006032) by John G. Holt, Noel R. Kreig, Peter Sneath, James Staley and Williams for up .. Free shipping on orders of $35+ from Target. Read reviews and buy Bergey's Manual of Determinative Bacteriology - 9 Edition by John G Holt (Hardcover) at ..
Get this from a library! Bergey's manual of determinative bacteriology. 9th ed. [John G Holt]. Grade 9–College. John G. Holt, PhD. 1994 (9th ed). 816 pages. Based on the data contained in the 4-volume Bergey's Manual of Systematic Bacteriology, this .. Jump to Bergey's Manual of Determinative Bacteriology Ninth Edition - Bergey's Manual of Determinative BacteriologyNinth Edition. Editor-in-Chief: .. Berge's Manual Of Determinative Bacteriology: Ninth Edition. Educational Materials Biology Educational Materials Biology Textbooks. John G. Holt et al. Based on the data contained in the four-volume Bergey's Manual of Systematic Bacteriology, BMDB-9 also includes new genera and species, new combinations .. Based on the data contained in the four-volume Bergey's Manual of Systematic Bacteriology, BMDB-9 also includes new genera and species, new combinations .. Bergey, D. H. 1860-1937., and John G Holt. Bergey's Manual of Determinative Bacteriology. 9th ed. Baltimore: Williams & Wilkins, 1993. Print. Note! Citation .. Shop our inventory for Bergey's Manual of Determinative Bacteriology - 9th Edition by D. Bergy, John G. Holt with fast free shipping on every used book we have .. Bergey's Manual® of Systematic Bacteriology. Volume Two: The Proteobacteria, Part A Introductory Essays. Editors; (view affiliations). Don J. Brenner; Noel R. The Biodiversity Heritage Library works collaboratively to make biodiversity literature openly available to the world as part of a global biodiversity community.
Based on the data contained in the four-volume Bergey's Manual of Systematic Bacteriology, BMDB-9 also includes new genera and species, new combinations .. The ninth edition of Bergey's Manual of Determinative Bacteriology is a departure from past editions that attempted, usually inadequately, to combine systematic .. Bergey, D. H. 1860-1937., and John G Holt. Bergey's Manual of Determinative Bacteriology. 9th ed. Philadelphia: Lippincott Williams & Wilkins, 2000. Print. Note!
Get this from a library! Bergey's manual of determinative bacteriology. 9th ed. [John G Holt]. Grade 9–College. John G. Holt, PhD. 1994 (9th ed). 816 pages. Based on the data contained in the 4-volume Bergey's Manual of Systematic Bacteriology, this .. Jump to Bergey's Manual of Determinative Bacteriology Ninth Edition - Bergey's Manual of Determinative BacteriologyNinth Edition. Editor-in-Chief: .. Berge's Manual Of Determinative Bacteriology: Ninth Edition. Educational Materials Biology Educational Materials Biology Textbooks. John G. Holt et al. Based on the data contained in the four-volume Bergey's Manual of Systematic Bacteriology, BMDB-9 also includes new genera and species, new combinations .. Based on the data contained in the four-volume Bergey's Manual of Systematic Bacteriology, BMDB-9 also includes new genera and species, new combinations .. Bergey, D. H. 1860-1937., and John G Holt. Bergey's Manual of Determinative Bacteriology. 9th ed. Baltimore: Williams & Wilkins, 1993. Print. Note! Citation .. Shop our inventory for Bergey's Manual of Determinative Bacteriology - 9th Edition by D. Bergy, John G. Holt with fast free shipping on every used book we have .. Bergey's Manual® of Systematic Bacteriology. Volume Two: The Proteobacteria, Part A Introductory Essays. Editors; (view affiliations). Don J. Brenner; Noel R. The Biodiversity Heritage Library works collaboratively to make biodiversity literature openly available to the world as part of a global biodiversity community.
Based on the data contained in the four-volume Bergey's Manual of Systematic Bacteriology, BMDB-9 also includes new genera and species, new combinations .. The ninth edition of Bergey's Manual of Determinative Bacteriology is a departure from past editions that attempted, usually inadequately, to combine systematic .. Bergey, D. H. 1860-1937., and John G Holt. Bergey's Manual of Determinative Bacteriology. 9th ed. Philadelphia: Lippincott Williams & Wilkins, 2000. Print. Note!

Universal termsrv patch windows 7. Bergey's manual of determinative bacteriology. Pages; Table of Contents Show More. URL for Current Page Scientific Names on this Page Indexed. Unlock my iphone without sim card.
Add weather to your Sims’ lives to tell new stories, enjoy seasonal activities, and celebrate heartfelt holidays with The Sims™ 4 Seasons. Make the most out of the weather all year round, from crisp snowfalls to sweltering heat – every world is affected by seasons in unique ways. Sims 4 update sims 4 codex.

Bergey's Manual Of Determinative Bacteriology Ninth Edition online, free
- 'bergey s manual of determinative bacteriology scribd may 9th, 2018 - bergey s manual of determinative bacteriology free download as pdf file pdf text file txt or read online for free' 'bergey s manual of systematic bacteriology in searchworks april 4th, 2018 - beginning date 1984 ending date 1989 note.
- Bergey's Manual of Determinative Bacteriology / Edition 9 by John G. Sneath (Editor), Noel R. I need this book for my researches and it will be very interesting for.
